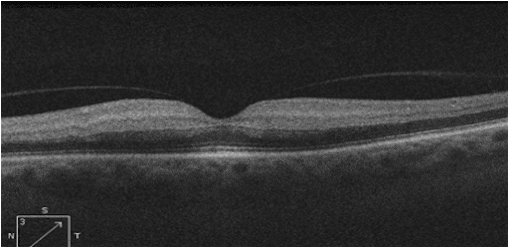

The OCT Academy
What are the 3 things wrong with this OCT?
(click on image for answer)
What to become an Expert Clinician?
- Weekly teaching (10-20 minute video sent electronically)
- Access to over 140 teaching videos on retinal cases!
- Regular testing
- Our Atlas of “crazy” cases (includes anterior segment, Peds, Neuro, etc…)
- And more…
Start 14-day Free Trial
What Optometrists say about Optocase
Since a colleague told me about optocase I have never missed one… My knowledge and understanding of retinal anatomy has grown exponentially!
Optocase has proven to be a valuable teaching/review tool for me. It continues to reinforce my knowledge base and broaden my OCT competency.
“By simply reading Dr. Sharma’s weekly OCT tips, my OCT interpretation skills have increased drastically, more so than from any other learning method.”
Start 14-day Free Trial
Want to Become a Master Clinician?

Relieve Your OCT Anxiety
Join our 16,000+ OD members and subscribe to our newsletter for a free weekly OCT tip.
Subscribe to the OCT Academy and you instantly get access to the entire back catalog of tips from the past 2 years.
Expert Level Learning
Get the next level OCT learning experience: video analysis with expert commentary, including an extensive case discussion, deep insight, and clinical pearls.

Diagnostic Confidence
Our searchable atlas contains over 100 must-know cases. Grow your knowledge in all areas of eye disease: retina, glaucoma, pediatrics, anterior segment, neuro, pathology, oculoplastics, and ocular emergencies.
Best In Class COPE CE
Never scramble for COPE credit again.
Our cases are clinically-based and highly recommended by our optom members. When you subscribe the COPE Package, you get access to 2 hours of CE every month, at 40% off.
